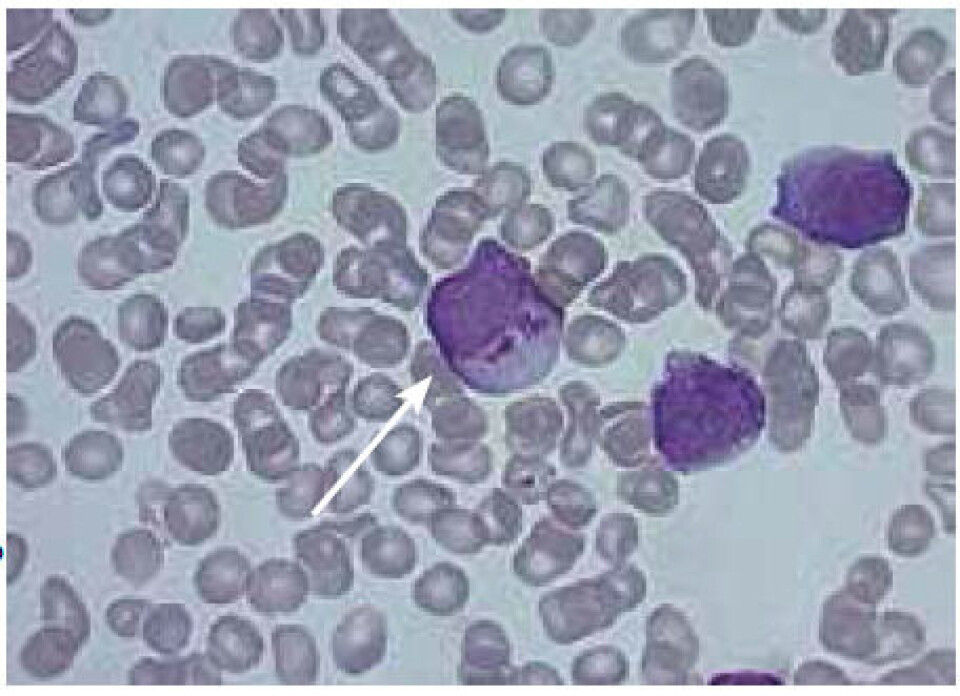
Figur 2
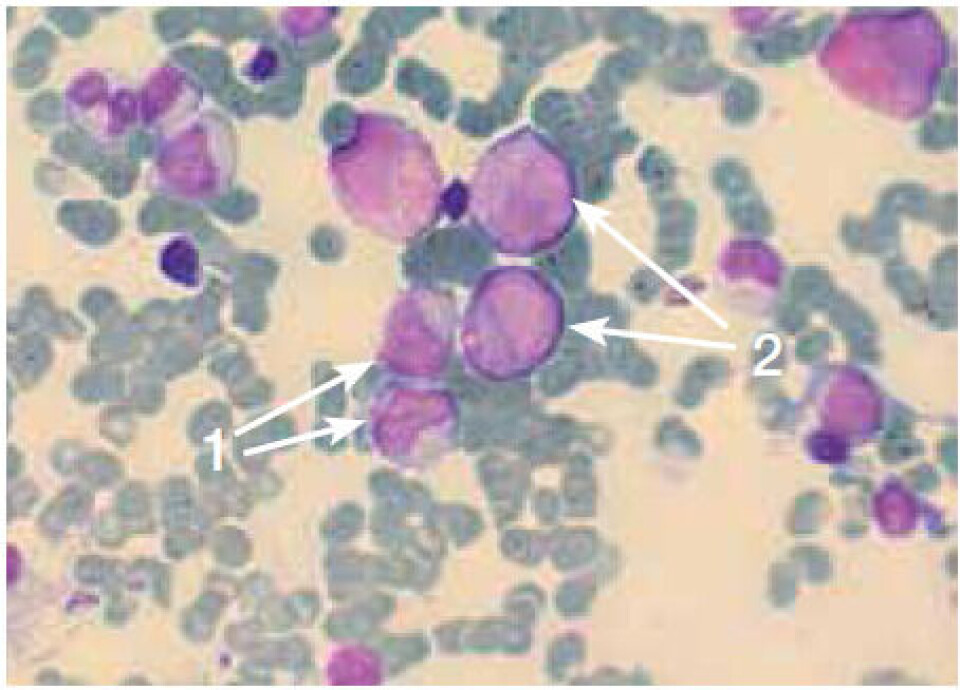
Figur 3

FAG i praksis
To pasienter innlagt med nøytropeni, men med ulike diagnoser
To pasienter - begge kvinner på cirka 70 år - kom inn i akuttmottaket med tiltagende slapphet og markert nøytropeni. Artikkelforfatterne fulgte pasientene fra innleggelse til diagnose og behandling.
To pasienter innlagt med nøytropeni, men med ulike diagnoser.pdf(245 KB)
Ved Avdeling for medisinsk biokjemi, Diakonhjemmet Sykehus, analyseres daglig prøver fra pasienter som kommer inn i akuttmottaket. Det legges utredningsplaner, og bioingeniører bidrar med å analysere ulike parametere og videresende prøver til spesialanalyser.
Bioingeniører får imidlertid sjelden vite noe om gangen i utredningen og hvilke funn og tanker som igjen fører til diagnose og dermed også riktig behandling av pasienten.
Her presenterer vi to kasuistikker hvor bioingeniørene har fulgt pasientene fra innleggelse til diagnose og behandling. Begge pasientene er kvinner på cirka 70 år som kommer inn i akuttmottaket med tiltagende slapphet og samtidig markert nøytropeni. Etter vurdering av celletellinger, blodutstryk og benmarg er det hos begge pasientene mistanke om akutt promyelocyttleukemi (AML M3).
Pasient 1
Pasienten er en kvinne på litt over 70 år. Hun hadde influensalignende symptomer for ni måneder siden og har de siste seks månedene følt seg tiltagende slapp og hatt redusert overskudd. Hun har siste døgnet hatt spontane hudblødninger og legges derfor inn for utredning.
Maskinell celletelling viser moderat nøytropeni: 0,9∙109/L (referanseområde: 1,5 - 7,5∙109/L). Samtidig viser blodutstryk at de fleste leukocyttene er umodne med mange store granula og påfallende mange Auerstav-liknende strukturer i cytoplasma. Utstryket viser også enkelte kjerneholdige røde blodceller.
Analysesvarene viser dessuten monocytose: 2,2∙109/L (referanseområde: 0,2 - 0,8), lav trombocyttverdi: 41∙109/L (referanseområde: 145-390∙109/L), forhøyet D-dimer: > 4,0 mg/L (referanseområde: 0,0-0,4 mg/L) og lav fibrinogenkonsentrasjon: 0,9 g/L (referanseområde: 1,7 - 4,0 g/L).
Innkomstverdiene og visuell vurdering av blod- og benmargutstryk gir betydelig mistanke om AML M3, ledsaget av en ukompensert disseminert intravaskulær koagulasjon (DIC).
Støtteverdier: Benmarg viser modningsstopp, ingen økning i blaster, 40-50 % promyelocytter og 10-15 celler med Auerstaver. Funn i benmarg er forenlig med AML M3. Dette ble bekreftet ved flowcytometri av benmarg.
Diagnose pasient 1: Akutt promyelocyttleukemi med DIC.
Behandling: Pasienten gis behandling etter modifisert standardprosedyre for pasienter over 70 år; vitaminderivatet all-trans retinsyre (ATRA) og cytostatika. Pasienten utvikler retinsyre syndrom (RAS) og starter derfor også med Dexamethason-behandling (kortison). Dette for å kunne gjennomføre livsnødvendig behandling med ATRA.
Dag 18: Pasienten behandles for nøytropen feber.
Etter cirka tre måneder er benmargen på god vei til å regenerere, men har fortsatt økt antall promyelocytter.
Etter hovedbehandlingen følger vedlikeholdsbehandling over to år. Den består av repeterende sykler med ATRA og cellegift (Purinethol og Metotrexat) og krever hyppig oppfølging med blodprøver (hvite/nøytrofile, ALAT og bilirubin).
Generelt om AML M3: Ved AML M3 er de fleste umodne celler promyelocytter med tung granulering, og det sees mange Auerstaver i hver celle. Det kritiske med AML M3 er at den regelmessig ledsages av en ukompensert DIC og uttalt blødningstendens. Sykdommen diagnostiseres ofte direkte med benmargsmorfologi.
Det er viktig å identifisere og påvise leukemien umiddelbart, da tidlig behandling med ATRA gir god sjanse for komplett hematologisk remisjon (KHR). ATRA komplementeres alltid med cytostatika.
ATRA er en normal bestanddel i plasma. Under behandlingen med ATRA forsvinner ledsagende ukompensert DIC ofte i løpet av en uke, og i løpet av noen uker eller to - tre måneder skjer en gradvis utmodning av promyelocyttene til modne granulocytter i benmargen. Etterhvert normaliseres perifert blod og benmarg, og nesten alle pasientene oppnår KHR.
Pasient 2
Pasienten er en kvinne på cirka 70 år som innlegges med nøytropen feber. De siste to månedene har hun vært plaget av slapphet, vekttap, munnsår og tørrhoste. Hun bruker ulike medisiner. De siste tre dagene har hun vært plaget med feber og nattesvette. På innleggelsesdagen har hun frostanfall.
Maskinell celletelling viser nøytrofile: 0,01∙109/L (referanseområde: 1,5 - 7,5∙109/L) og monocytose: 1,3∙109/L (referanseområde: 0,2 - 0,8∙109/L). Innkomstverdiene kan gi mistanke om AML M3 fordi benmargsundersøkelse viser opphopning av promyelocytter med modningsstopp, nesten ingen modne granulocytter, men mange eosinofile granulocytter.
Benmargsbildet er likevel ikke så monotont som en ville forvente ved AML M3. Erytropoiesen er normal, og det er ingen påvirkning av andre cellelinjer.
Normalt antall trombocytter og normal fibrinogenkonsentrasjon utelukker DIC.
Bildet kan være forenlig med AML M3 eller medikamentindusert margpåvirkning med modningsstopp. Prøver sendes til flowcytometri for videre undersøkelser.
Det lyktes ikke å sikre vanlig benmargsbiopsi fra hoftekammen på grunn av fedme. Det ble derfor utført sternalpunksjon (brystben).
Det ble også målt CRP: 84 mg/L (referanseområde: < 4 mg/L). Influensa hurtigtest og monotest var begge negative.
Støtteverdier: Flowcytometri av benmarg viser avvikende fordeling av cellene med nedsatt granulopoiese som er venstreforskjøvet med 27 prosent promyelocytter, samt modningsstopp på metamyelocyttstadiet. Den viser også reaktiv eosinofili (6 - 7 prosent av totale celler), monocytose (15,5 prosent), lymfocytose (52 prosent) og høy normalandel av erytroide celler (12 - 15 prosent).
Flowcytometri av perifert blod viser 58,7 prosent lymfocytter, 33,7 prosent monocytter og 5,0 prosent granulocytter. Disse funnene er forenlig med toksisk granulocytopeni.
Dette tyder på en sekundær nøytropeni som er immunmediert, sannsynligvis på grunn av medikamenter eller infeksjon. Pasienten har ved flere anledninger vært behandlet med ulike typer antibiotika og naturmedisinen ”Heilerde” (en spesiell type jord som røres ut i vann og inntas). Man kan ikke med sikkerhet si hvilket preparat som er årsak til nøytropenien. Hun har brukt andre medikamenter over flere år.
Diagnose pasient 2: Medikamentindusert margpåvirkning med modningsstopp på metamyelocyttstadiet.
Behandling: Dagen etter innleggelsen behandles pasienten med intravenøs penicillin og gentamycin, som er standard behandling ved febril nøytropeni.
Dag 4: Pasienten er i god allmenntilstand og er feberfri. Penicillindosen reduseres, men pasienten beholdes i beskyttende isolat fordi hun fortsatt har markert nøytropeni.
Dag 6: Pasienten er klinisk kjekkere. Medikamentet Esomeprazol (Nexium) seponeres fordi nøytropeni er en kjent bivirkning. Pasienten er snart utskrivningsklar.
Dag 7: Pasienten skrives ut, fortsatt med kun 0,2∙109/L i nøytrofile, men tendensen er stigende.
Generelt om medikamentindusert nøytropeni: Ved alvorlig kronisk nøytropeni er antall sirkulerende nøytrofile granulocytter redusert til mindre enn 0,5∙109/L i mer enn tre måneder. Infeksjon er hovedfaren ved akutt medikamentindusert nøytropeni, og feber er ofte det eneste kliniske tegnet. Av og til sees også nøytropen gingivitt/stomatitt (tannkjøttsykdom).
Behandlingen er å seponere medikamenter som kan mistenkes å forårsake nøytropenien. Ved feber skal pasienten isoleres i beskyttende hensikt og behandles med intravenøs antibiotika.
Konklusjon
To pasienter med nøytropeni med modningsstopp viser seg å ha to ulike diagnoser, henholdsvis AML M3 og medikamentindusert benmargspåvirkning. Avgjørende for diagnostikken var maskinell celletelling, mikroskopi av blod og benmarg og evaluering av blodprøver forøvrig, spesielt koagulasjonsstatus. Utover dette har en grundig medikamentanamnese hatt betydning.
I ettertid har begge pasientene normale blodbilder.
Utfyllende litteratur
- Evensen SA, Brinch L, Tjønnfjord GE, Wisløff F. Blodsykdommer. Oslo: Universitetsforlaget; 1999.
- Hoffbrand AV, Moss PAH, Petit LE. Essential Haemaetology. Fifth edition. Malden: Blackwell Publishing; 2006. s. 12-27.
- Philipsen JP. Maligne blodsykdommer, laboratoriediagnostikk. Hillerød; 2010.
- www.legemiddelhåndboka.no.